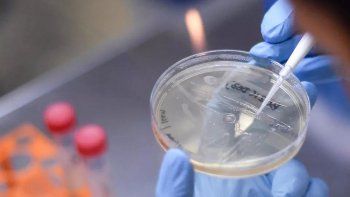
la cepa delta del covid-19 es hasta un 60% mas contagiosa la cepa delta del covid-19 es hasta un 60% mas contagiosa

Éstos son los síntomas que indican que ya tuviste COVID
A pesar de que la pandemia del COVID lleva más de un año, cada día los científicos descubren nuevas características del virus. En este sentido, una investigación publicada el 19 de febrero en la revista médica JAMA Network Open arroja algo de luz sobre este enigma que se ha denominado “covid largo”, “covid prolongado”, “síndrome pos-covid” o “síndrome pos-covid agudo”.
De manera simple, las personas contagiadas de COVID pueden sufrir síntomas o efectos a largo plazo. Sin importar la gravedad de la enfermedad que atravesaron cuando se contagiaron. “En algunas personas, algunos síntomas pueden persistir o volver a aparecer por semanas o meses luego de la recuperación inicial. Esto también puede ocurrirle a personas con una enfermedad leve”, indicó la Organización Mundial de la Salud (OMS) en un documento publicado en septiembre de 2020. Además, la OMS detalló que la persistencia de los síntomas puede ocurrir independientemente de si se ha necesitado o no atención hospitalaria.
Pero, ¿cuáles son las señales o síntomas indican que una persona ya tuvo COVID? La fatiga es uno de los síntomas más comunes de la infección por COVID y también uno de los que más perdura, según los Centros para el Control y la Prevención de Enfermedades de Estados Unidos (CDC). Una investigación publicada el 19 de febrero en la revista Jama Network Open encontró que más del 30% de los 177 participantes que siguió por 9 meses reportaron síntomas persistentes. La fatiga fue lo más común, junto a la pérdida del olfato o gusto. Todas las personas que participaron en este estudio, realizado por investigadores de la Universidad de Washington, tuvieron coronavirus confirmado por pruebas de laboratorio. El 30% también informó una peor calidad de vida, en comparación con el momento anterior a contraer el nuevo coronavirus. Y el 8% de los participantes indicó que tenía problemas para realizar al menos una actividad cotidiana, como tareas diarias en la casa.
Otro estudio que siguió a más de 1.700 pacientes de COVID en Wuhan, el epicentro original de la pandemia en China, registró que el 76% sufrió al menos un síntoma meses después de ser dados de alta del hospital. ¿Los más comunes? Fatiga y dificultades para dormir, con el 63% y 26%, respectivamente, de los pacientes reportándolos medio años después de su diagnóstico inicial de COVID.
“Cuando miramos a los síntomas a largo plazo las grandes cosas que vemos son fatiga, letargo y trastornos del sueño. Y eso representa probablemente más de la mitad de lo que vemos”, señaló en diálogo con la CNN el doctor Christian Sandrock, profesor de medicina en cuidados intensivos pulmonares y enfermedades infecciosas en la Facultad de Medicina de la Universidad de Califonia en Davis, California. También advirtió que muchos pacientes experimentan múltiples síntomas, y que estos pueden ser intermitentes.
Los pacientes que sufren de efectos a largo plazo del COVID enfrentan, en gran medida, una condición que se conoce como confusión o “niebla” mental. Este fenómeno se está percibiendo de manera global. Así, por ejemplo, Caroline Gurvich, subdirectora del Centro de Investigación de Psiquiatría Monash Alfred en Melbourne, ha confirmado su existencia. “Es algo real, aunque no se reconoce formalmente como una condición médica o psicológica. Intentamos definirlo como un concepto de las personas comunes utilizado para describir disminuciones sutiles en la atención, concentración, memoria y toma de decisiones: una confusión mental o falta de claridad”.
La doctora Allison Navis, señaló a la CNN que la confusión mental “es un síntoma, no un diagnóstico. Y significa muchas cosas distintas para diferentes personas. Con frecuencia es una combinación de problemas de memoria a corto plazo, concentración o dificultad para expresarse”.
Estar alertas a las señales en la piel puede ayudar a saber si una persona tuvo COVID. Un análisis del Hospital General de Massachusetts, encontró que algunas personas contagiadas con el virus tuvieron síntomas relacionados con la piel tiempo después de su infección inicial. Esas señales en la piel se podían extender por hasta 60 días o más. El equipo evaluó casi 1.000 casos de pacientes con diversas manifestaciones coronavirus en la piel, como erupciones de urticaria, papuloescamosas e inflamación de manos y pies. La persistencia de estas condiciones se extendió desde los 12 hasta los 130 días, dependiendo del caso. “Nuestros hallazgos revelan un subconjunto no reportado previamente de pacientes con síntomas cutáneos de larga duración por COVID-19, en particular aquellos con ‘pies de covid’”, dijo el hospital en un comunicado. Y añadieron: “La piel es una ventana visible potencial a la inflamación que podría estar ocurriendo en el cuerpo”.
En cuanto a los efectos psicológicos, un estudio que siguió a 1.700 pacientes de COVID en China por seis meses también encontró que el virus podría tener complicaciones psicológicas duraderas, con ansiedad o depresión en el 23% de los participantes. En ese sentido, los hallazgos de esta investigación sobre fatiga, dificultades para dormir y ansiedad o depresión encajan con estudios anteriores sobre pacientes que tenían un coronavirus relacionado que causó el síndrome respiratorio agudo severo (SARS) en 2003 y 2004, según los investigadores chinos. Además, la depresión fue uno de los síntomas a largo plazo que registraron los CDC sobre el COVID-19.
Otros síntomas que pueden persistir tras tener COVID son: Dolores de cabeza y cuerpo, dolor en las articulaciones, diarrea, náuseas, dolor de pecho o abdominal, latidos rápidos o fuertes del corazón, erupciones o pérdida del cabello.
Te puede interesar...